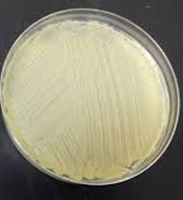
Bacterial lawn on agar plate
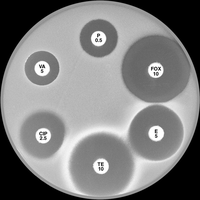
Kirby-Bauer plate with multiple antibiotics

Back
BackControl of Microbial Growth and Food Microbiology: Study Notes
Study Guide - Smart Notes

Control of Microbial Growth
Introduction and Key Definitions
Controlling microbial growth is essential in clinical, laboratory, and food settings to prevent infection, contamination, and spoilage. Several terms are fundamental to understanding these processes:
Sterilization: The complete destruction or removal of all forms of microbial life, including bacterial endospores. Typically achieved by physical methods such as heat or radiation.
Disinfection: The reduction of microbial populations on inanimate surfaces to safe levels, usually by chemical agents called disinfectants.
Antisepsis: The reduction of microbial populations on living tissue to safe levels, typically using antiseptics.
“-cidal” agents: Substances that kill microorganisms (e.g., bactericidal, fungicidal).
“-static” agents: Substances that inhibit microbial growth without killing (e.g., bacteriostatic).
Physical Methods of Microbial Control
Physical methods are commonly used to control microbial growth, especially for sterilization and disinfection.
Heat:
Dry Heat: Kills by oxidation of cell components. Requires high temperatures and long exposure (e.g., 2 hours at 160°C or 1 hour at 170°C). Used for glassware and metal instruments.
Moist Heat (Autoclaving): Kills by denaturing proteins and disrupting membranes. Uses steam under pressure (121°C, 15 psi, 15 min). Suitable for glass, metal, some plastics, and liquids.
Pasteurization: Gentle heating to reduce microbial load in foods (e.g., 62.9°C for 30 min or 71.6°C for 15 sec). Preserves taste and quality.
Radiation:
Non-ionizing (UV) Radiation: Causes DNA damage by forming thymidine dimers. Effective for surface disinfection (optimal at 260 nm).
Ionizing Radiation: (X-rays, gamma rays) Induces double-stranded DNA breaks. Used for sterilizing medical supplies and food packaging.
Filtration: Physically removes microbes from liquids using filters (0.45 or 0.22 μm pores). Used for heat-sensitive solutions.
Chemical Methods of Microbial Control
Chemical agents can act as disinfectants, antiseptics, or sterilants depending on their concentration and exposure time. Common chemicals include alcohols, phenolics, halogens, and aldehydes.
Chemotherapeutic Agents
Chemotherapeutic agents are chemicals that inhibit or kill microorganisms at concentrations tolerated by the host (selective toxicity).
Antibiotics: Naturally occurring or synthetic agents that inhibit or kill bacteria. Many are derived from sporulating organisms and can be chemically modified for improved efficacy.
Antimycotics: Agents that target fungi (yeasts and molds).
Antivirals: Agents that inhibit viral replication within host cells.
Antimicrobial Susceptibility Testing
Purpose and Overview
Antimicrobial susceptibility testing determines the effectiveness of antimicrobial agents (disinfectants, antiseptics, antibiotics) against specific microorganisms. This guides clinical therapy and infection control.
Use-Dilution Test
This test evaluates the effectiveness of disinfectants by exposing standardized bacterial cultures to different concentrations of the chemical and assessing survival.
Kirby-Bauer Disk Diffusion Method
The Kirby-Bauer method is a standardized assay to assess the susceptibility of bacteria to antimicrobial agents using impregnated paper discs on an agar surface.
Preparation: A 0.5 McFarland standard (approx. 1.5 x 108 CFU/mL) is used to standardize the bacterial inoculum.
Inoculation: Mueller-Hinton agar is swabbed in three directions to create a uniform lawn of bacteria.
Disc Placement: Filter discs containing known amounts of antimicrobial agents are placed on the agar surface in a radial pattern.

Critical Parameters for Kirby-Bauer Method
Inoculum Density: Must match the 0.5 McFarland standard. Too little or too much bacteria can skew results.
Agar Depth: Mueller-Hinton agar must be 4 mm deep. Incorrect depth affects diffusion and zone size.
Disc Contact: Discs must be fully in contact with the agar for proper diffusion.
Interpreting Results: Zone of Inhibition
After incubation, clear zones (zones of inhibition) appear around effective agents. The diameter of these zones is measured in millimeters and is proportional to the agent's effectiveness.

Example: Ranking Antibiotic Effectiveness
Discs labeled with antibiotics (e.g., P = penicillin, FOX = cefoxitin, E = erythromycin, TE = tetracycline, CIP = ciprofloxacin, VA = vancomycin) are compared by measuring their zones of inhibition. The largest zone indicates the most effective antibiotic against the tested bacterium.
Food Microbiology I
Introduction and Public Health Significance
Food microbiology involves the study of microorganisms in food, including those that cause spoilage and disease. Quantitative methods are used to determine microbial population density in food products, which is critical for public health and safety.
Each year, millions of people are affected by food-borne illnesses, leading to hospitalizations and deaths.
Regulations set limits on total bacterial counts and specific pathogens in foods.
Viable Plate Count Method
This method estimates the number of viable bacteria in a food sample by serial dilution and plating.
Step 1: Transfer 1 mL of milk to 9 mL of diluent (1:10 dilution).
Step 2: Transfer 1 mL of the 1:10 dilution to 99 mL of diluent (1:100 of 1:10 = 1:1000 total dilution).
Step 3: Plate 1 mL of dilution onto agar and spread evenly.

Food Microbiology II: Microbial Food Production
Beneficial Microorganisms in Food
Not all microorganisms in food are harmful; some are essential for food production and human health.
Examples: Lactobacillus spp. in yogurt, edible mushrooms, and microbes used in cheese and alcoholic beverage production.
Fermentative Metabolism in Food Production
Fermentation by bacteria and yeasts is central to the production of many foods. Two main pathways are relevant:
Homolactic Fermentation: Pyruvate is reduced to lactic acid by lactate dehydrogenase (LDH).
Alcoholic Fermentation: Acetaldehyde is reduced to ethanol by acetaldehyde dehydrogenase (ADH).

Yogurt Production
Yogurt is produced by the bacterial fermentation of milk sugar (lactose) using Lactobacillus bulgaricus and Streptococcus thermophilus. The process involves:
Lactase enzyme hydrolyzes lactose into glucose and galactose.
Fermentation of glucose produces lactic acid, which gives yogurt its tart taste and causes milk proteins to curdle (forming curds and whey).
Summary Table: Physical and Chemical Methods of Microbial Control
Method | Mechanism | Application |
|---|---|---|
Dry Heat | Oxidizes proteins/lipids | Glassware, metal tools |
Moist Heat (Autoclave) | Denatures proteins/membranes | Media, liquids, some plastics |
Pasteurization | Reduces microbial load | Milk, juices |
UV Radiation | DNA damage (thymidine dimers) | Surface disinfection |
Ionizing Radiation | DNA double-strand breaks | Medical supplies, food packaging |
Filtration | Physical removal | Heat-sensitive liquids |
Chemical Agents | Varies (protein denaturation, membrane disruption, etc.) | Surfaces, skin, instruments |
Key Equations
Serial Dilution Calculation:
Original Cell Density (OCD):
Additional info: The notes above include expanded academic context and explanations to ensure completeness and clarity for microbiology students.
